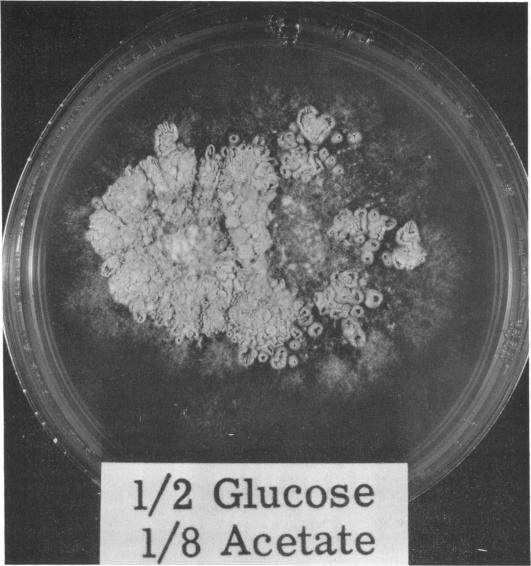
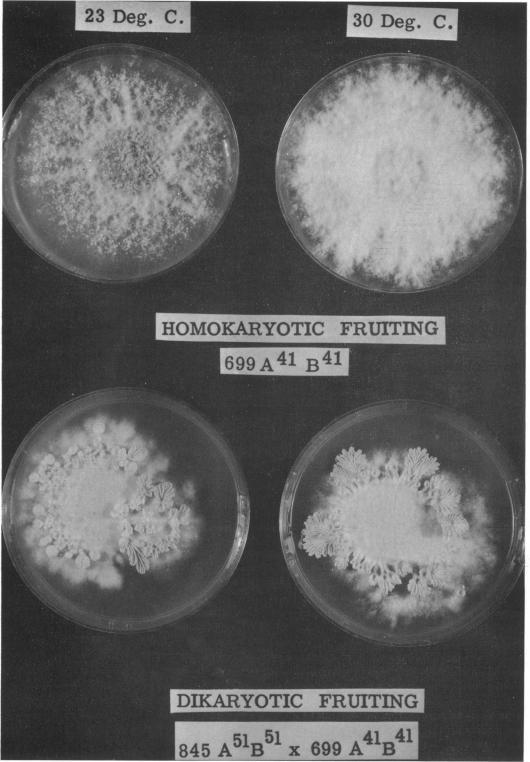

裂褶菌发育的营养研究
NUTRITIONAL STUDIES OF DEVELOPMENT IN SCHIZOPHYLLIUM COMMUNE.
作者信息
NIEDERPRUEM D J, HOBBS H, HENRY L
出版信息
J Bacteriol. 1964 Dec;88(6):1721-9. doi: 10.1128/jb.88.6.1721-1729.1964.
Niederpruem, Donald J. (Indiana University Medical Center, Indianapolis), Hudner Hobbs, and Lyle Henry. Nutritional studies of development in Schizophyllum commune. J. Bacteriol. 88:1721-1729. 1964.-Individual carbon and nitrogen sources which sustain dikaryotic fruiting in the basidiomycete Schizophyllum commune were determined. Combination studies indicated that certain poor substrates were inhibitory; these included acetate, citrate, KNO(2), and l-lysine. Homokaryotic (haploid) fruiting was promoted by dilute culture medium. Both developmental systems were arrested by respiratory CO(2). Elevated temperature (e.g., 30 C) essentially completely blocked homokaryotic fruiting of S. commune.
尼德普吕姆,唐纳德·J.(印第安纳大学医学中心,印第安纳波利斯),哈德纳·霍布斯和莱尔·亨利。裂褶菌发育的营养研究。《细菌学杂志》88:1721 - 1729。1964年。——确定了在担子菌裂褶菌中维持双核体结实的单个碳源和氮源。组合研究表明某些劣质底物具有抑制作用;这些包括乙酸盐、柠檬酸盐、亚硝酸钾和L - 赖氨酸。稀释培养基促进同核体(单倍体)结实。两种发育系统都被呼吸产生的二氧化碳所抑制。高温(例如30℃)基本上完全阻断了裂褶菌的同核体结实。